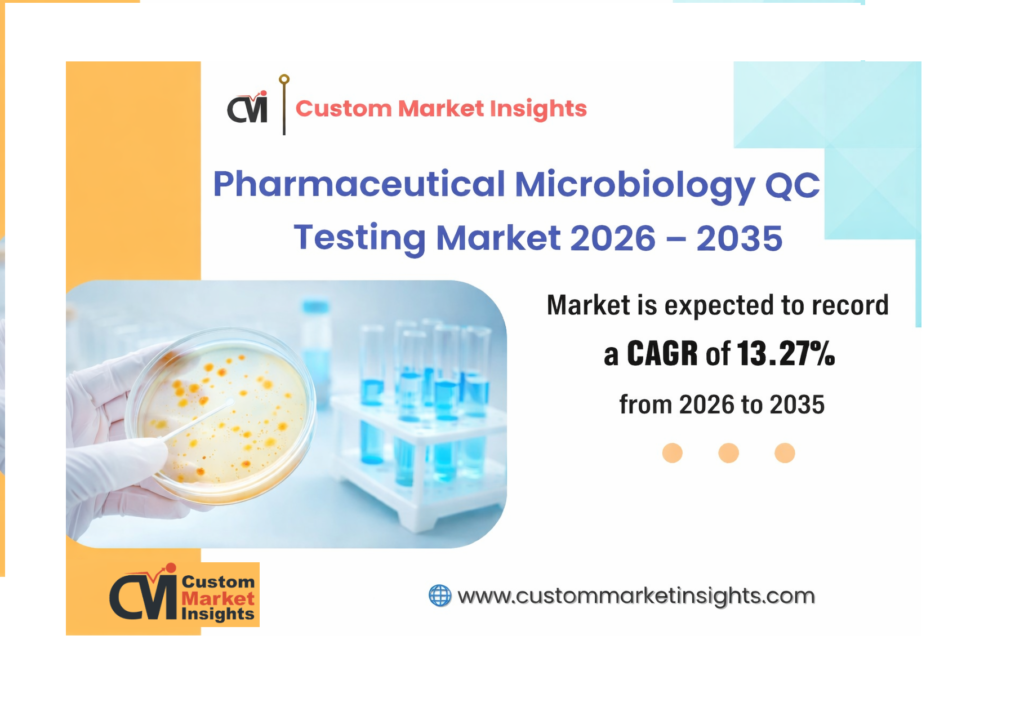
Pharmaceutical Microbiology QC Testing

The global Pharmaceutical Microbiology QC Testing Market is entering a phase of accelerated expansion, driven by stringent regulatory requirements, increasing pharmaceutical production, and the growing need for contamination-free drug development. According to the latest analysis by the CMI team, the market is projected to grow at a CAGR of 13.27% from 2026 to 2035, rising from USD 5.75 Billion in 2026 to approximately USD 17.65 Billion by 2035.
Rising Importance of Microbiological Quality Control
Pharmaceutical microbiology quality control (QC) testing plays a crucial role in ensuring the safety, efficacy, and compliance of pharmaceutical products. From raw material testing to final product validation, microbiological QC testing helps detect harmful microorganisms and ensures that products meet global regulatory standards. With the increasing complexity of drugs, especially biologics and injectable therapies, the importance of robust QC testing has become more critical than ever.
Growing concerns around contamination risks, product recalls, and patient safety are compelling pharmaceutical companies to invest heavily in advanced microbiological testing solutions. Regulatory authorities such as the FDA and EMA have also intensified their guidelines, further driving the adoption of reliable and high-precision testing methods.
Market Drivers Fueling Growth
One of the key factors driving the market is the rapid expansion of the pharmaceutical and biotechnology industries. The rise in biologics, biosimilars, and vaccine production has significantly increased the demand for microbiological QC testing. These products are highly sensitive to microbial contamination, requiring stringent testing protocols throughout the manufacturing process.
Additionally, the growing trend of outsourcing QC testing to contract research organizations (CROs) and contract manufacturing organizations (CMOs) is contributing to market growth. These service providers offer specialized expertise and advanced infrastructure, enabling pharmaceutical companies to streamline operations and reduce costs.
Technological advancements are also playing a vital role in market expansion. The integration of automation, digital tools, and artificial intelligence (AI) is enhancing testing accuracy, reducing turnaround time, and improving data management. Rapid microbiological methods (RMMs) are gaining traction as they offer faster and more reliable results compared to traditional culture-based techniques.
Segmental Analysis
The pharmaceutical microbiology QC testing market is segmented based on product, test type, technique, and application, each contributing uniquely to overall market growth.
By product, the market includes instruments, reagents & kits, accessories, and software. Reagents and kits dominate the segment due to their recurring demand in testing procedures. Meanwhile, advanced instruments and automated systems are witnessing increasing adoption as companies focus on improving efficiency and minimizing human error.
In terms of test type, the market is categorized into conventional/traditional testing and rapid testing. While traditional methods remain widely used due to regulatory acceptance, rapid testing methods are gaining momentum for their ability to deliver faster results and enhance operational efficiency.
Based on technique, the market encompasses growth-based testing, nucleic acid-based testing, cellular component-based testing, and viability-based testing. Among these, nucleic acid-based techniques such as PCR are gaining popularity due to their high sensitivity and accuracy in detecting microbial contamination.
The application segment includes bioburden testing, sterility testing, environmental monitoring, endotoxin testing, pyrogen testing, mycoplasma testing, and microbial identification. Sterility and bioburden testing hold significant importance, particularly in ensuring product safety and compliance. Environmental monitoring is also emerging as a key focus area, especially in cleanroom manufacturing environments.
Regional Insights
Regionally, North America dominates the pharmaceutical microbiology QC testing market, supported by a strong pharmaceutical industry, advanced research infrastructure, and strict regulatory frameworks. The United States remains a key contributor due to the presence of major pharmaceutical companies and leading testing solution providers.
Europe follows closely, with increasing investments in research and development and a well-established regulatory environment. Meanwhile, the Asia-Pacific region is expected to witness the fastest growth during the forecast period. Factors such as expanding pharmaceutical manufacturing, rising healthcare expenditure, and increasing awareness of quality standards are driving market growth in countries like China and India.
Competitive Landscape
The pharmaceutical microbiology QC testing market is highly competitive, with several global and regional players striving to enhance their market position through innovation and strategic collaborations. Key companies operating in the market include:
- Thermo Fisher Scientific Inc.
- BD
- Merck KGaA
- bioMérieux SA
- Danaher
- Sartorius AG
- Rapid Micro Biosystems Inc.
- Charles River Laboratories
- HiMedia Laboratories
- Hardy Diagnostics
These players are focusing on expanding their product portfolios, investing in advanced technologies, and forming strategic partnerships to gain a competitive edge in the market.
Emerging Trends and Opportunities
The shift towards rapid microbiological methods is one of the most notable trends in the market. These methods significantly reduce testing time, enabling faster product release and improved efficiency. Additionally, the increasing adoption of automation and digital solutions is transforming laboratory workflows and enhancing overall productivity.
Another emerging trend is the growing use of artificial intelligence and data analytics in microbiological testing. These technologies are enabling better interpretation of complex data, improving decision-making, and ensuring regulatory compliance.
Furthermore, the rising focus on personalized medicine and advanced therapies is expected to create new opportunities for microbiological QC testing. As drug formulations become more complex, the need for precise and reliable testing methods will continue to grow.
Future Outlook
The future of the pharmaceutical microbiology QC testing market looks highly promising, with strong growth potential driven by technological advancements and increasing demand for high-quality pharmaceutical products. While challenges such as high costs and regulatory complexities persist, ongoing innovations and supportive regulatory frameworks are expected to address these issues.
In conclusion, the market is set to play a pivotal role in ensuring drug safety and quality in an increasingly complex pharmaceutical landscape. As companies continue to prioritize compliance and patient safety, the demand for advanced microbiological QC testing solutions is expected to rise significantly, creating substantial opportunities for industry stakeholders over the coming years.